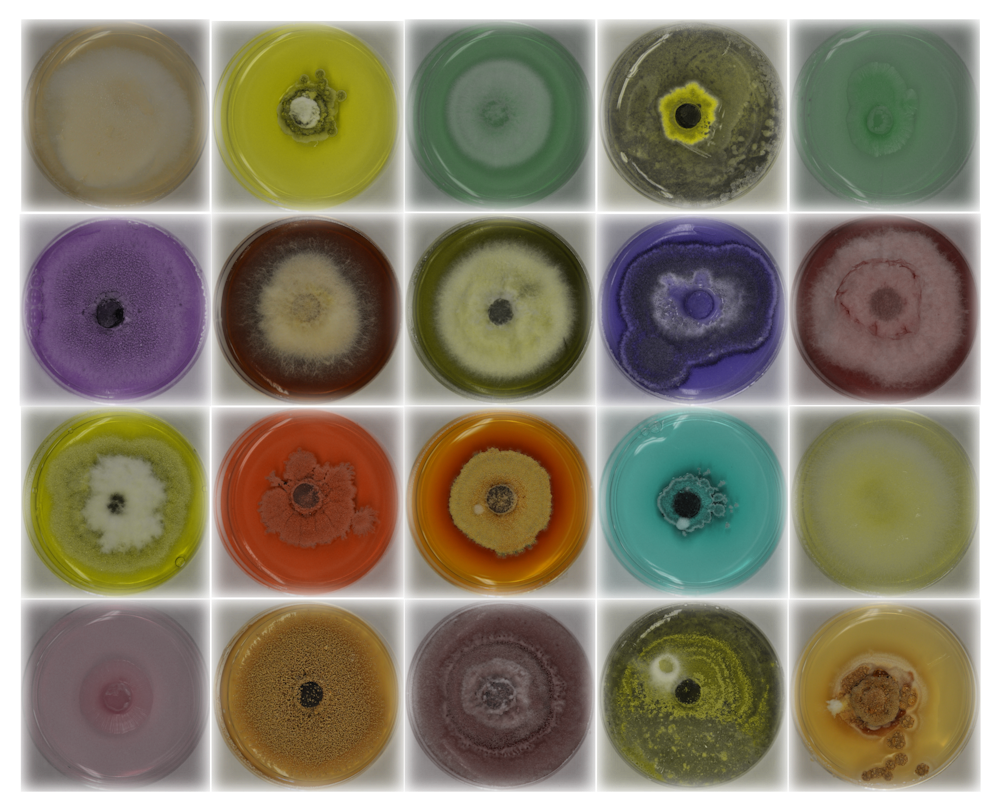
Death Road To Canada Crack Death Road To Canada Crack

Death Road to Canada is a Randomly Generated Road Trip Action-RPG. You manage a group of jerks as they explore cities, find weird people, and face up to 500 zombies at once. Everything's randomized: locations, events, survivor personalities and skills. There's a different story every time you play. Adobe suite download free. full mac. After all, you can't make it to Canada if you die! For less dangerous seiges, simply bring a pistol and a shotgun. Don't use the shotgun too much, but don't be afraid to bring it along if there are a lot of zombies you're going to have to kill. The Slug Shotgun is basically a rifle that uses shotgun ammo.
๐ APK Description
Death Road to Canada is an incredibly cool pixel-based action game from Noodlecake Studios with randomly generated events, high difficulty level, and the characterโs almost guaranteed death from the bites of thousands of zombies in its path. Only someone who is extremely lucky, careful and making the necessary decisions, even if they are far from moral standards, will be able to make it to Canada, where, as everyone knows, it is very cool, which means zombies there. are uncomfortable. to Canada is a randomly generated road RPG action-role-playing game. You manage a group of goons as they explore towns, find strange people, and take on up to 500 zombies at a time. Everything is random: places, events, personalities and skills of the survivors. There is a different story every time you play.
Holdem manager 2 for mac os.
๐ฎ APK MOD Features:
Here's what's hacked in this mod apk: a lot of money
Philips gogear vibe software download mac.
โ๏ธ Technical Information:
Minimum Android Version Required:- 4.0 and newer versions of Android
Supported Android Version
-Jelly Bean(4.1โ4.3.1)- KitKat (4.4โ4.4.4)- Lollipop (5.0โ5.0.2) โ Marshmallow (6.0 โ 6.0.1) โ Nougat (7.0 โ 7.1.1) โ Oreo (8.0-8.1) โ Pie (9.0)

๐ฅ Direct download link for Death Road to Canada v1.6.3 Mod APK a lot of money APK for Android:
๐๏ธ Alternative MOD APK Versions:
Death Road To Canada Cracking
โข Death Road to Canada 1.6.3 Mod a lot of moneyDeath Road To Canada Hacked
โข Death Road to Canada 1.4.0 FULL APK
๐ท๏ธ Tags:
death road to canada mod apk, death road to canada cheats, death road to canada hack, freedeath road to canada cheat, death road to canada download apk cracked, death road to canada crack, death road to canada injection, death road to canada working hack